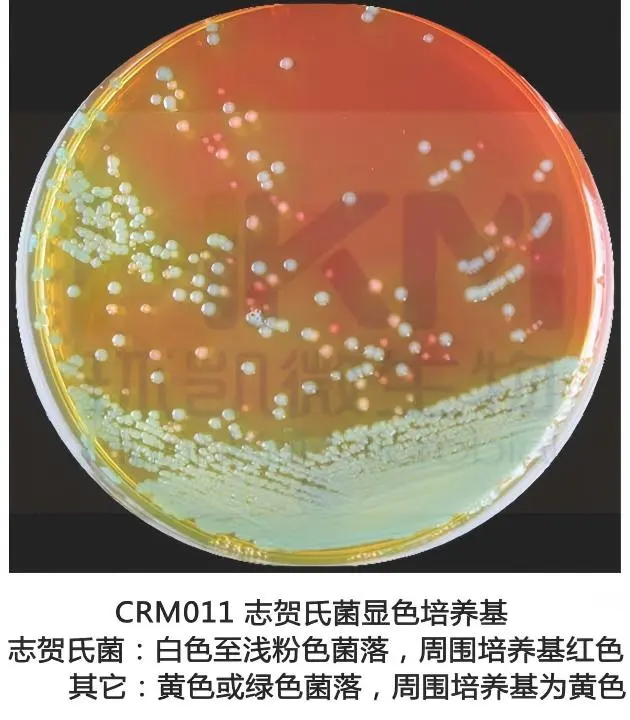

商品详细
行业应用
相关论文
说明书
培训资料
相关视频
产品名称:志贺氏菌显色培养基
英文名称:Chromogenic Shigella Agar
产品编号与包装规格:
| 产品编号 | 产品类型 | 包装规格 |
|---|---|---|
| CRM011 | 干粉 | 1000mL/瓶 |
| SR0440(无需额外购买) | 配套试剂 | 1瓶 |
产品用途:用于志贺氏菌的选择性分离和初步鉴别。
检验原理:蛋白胨和酵母膏粉提供碳氮源和微量元素;氯化钠可维持均衡的渗透压;琼脂是培养基的凝固剂;抑制剂抑制杂菌的生长;酚红是pH指示剂,发酵糖产酸的菌呈黄色;混合色素对应的酶发生特异性反应,水解底物,释放出显色基团。
志贺氏菌显色培养基配方成分:
| 成分 | 含量(每升) |
|---|---|
| 蛋白胨 | 9.0g |
| 酵母膏粉 | 3.0g |
| 氯化钠 | 5.0g |
| 糖类 | 15.0g |
| 蒸馏水 | 1000mL |
| 琼脂 | 15.0g |
| 抑菌剂 | 2.0g |
| 酚红 | 0.1g |
| 混合色素 | 2.1g |
| 最终pH | 6.8±0.2(25℃) |
使用方法:称取基础培养基51.2g,加入蒸馏水或去离子水970mL,搅拌加热煮沸至完全溶解,待冷至50℃左右。用30 mL蒸馏水或去离子水溶解1瓶添加剂(SR0440),充分混匀直至溶液变成淡黄色,使用0.45 μm或0.22 μm的滤膜过滤除菌,无菌操作加入到已冷却至50~55℃的970 mL培养基基础中(可按比例扩大或缩小),充分混匀后倾注灭菌平皿,待凝固后,备用。
志贺氏菌显色培养基质量控制【下列质控菌株接种后于37℃培养20-24h,观察结果如下表:】:
| 指标 | 质控菌株及编号 | 标准值 | 特征性反应 |
|---|---|---|---|
| 生长率 | 福氏志贺氏菌CMCC(B)51572 | PR≥0.5 | 白色至粉红色的菌落, 周围培养基变为红色 |
| 痢疾志贺氏菌CMCC(B)51105 | 白色至粉红色的菌落, 周围培养基变为红色 | ||
| 特异性 | 产气肠杆菌ATCC 13048 | —— | 绿色菌落,无环和沉淀圈 |
| 大肠埃希氏菌ATCC25922 | 黄色菌落,有清晰环,无色素沉淀圈 | ||
| 选择性 | 金黄色葡萄球菌ATCC6538 | G≤1 | —— |
储存条件与保质期:基础培养基和添加剂贮存于2-8℃避光、干燥处。在标签注明的保质期内使用。添加剂溶解过滤后2-8℃避光至多可保存3个月。
